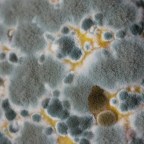
Женщине поставили диагноз рак: ее годами медленно отравлял кухонный прибор

Привет! Про скучные взрослые дела
За последнее время в блоге и подкасте стало заметно больше читателей и слушателей. Это очень радует, хотя и не приносит никакой материальной выгоды. Блог и подкаст «Сто растений, которые нас убили» продолжают жить только потому, что их кто-то слушает, читает, пересылает друзьям и вообще считает нужными. Читать далее Привет! Про скучные взрослые дела